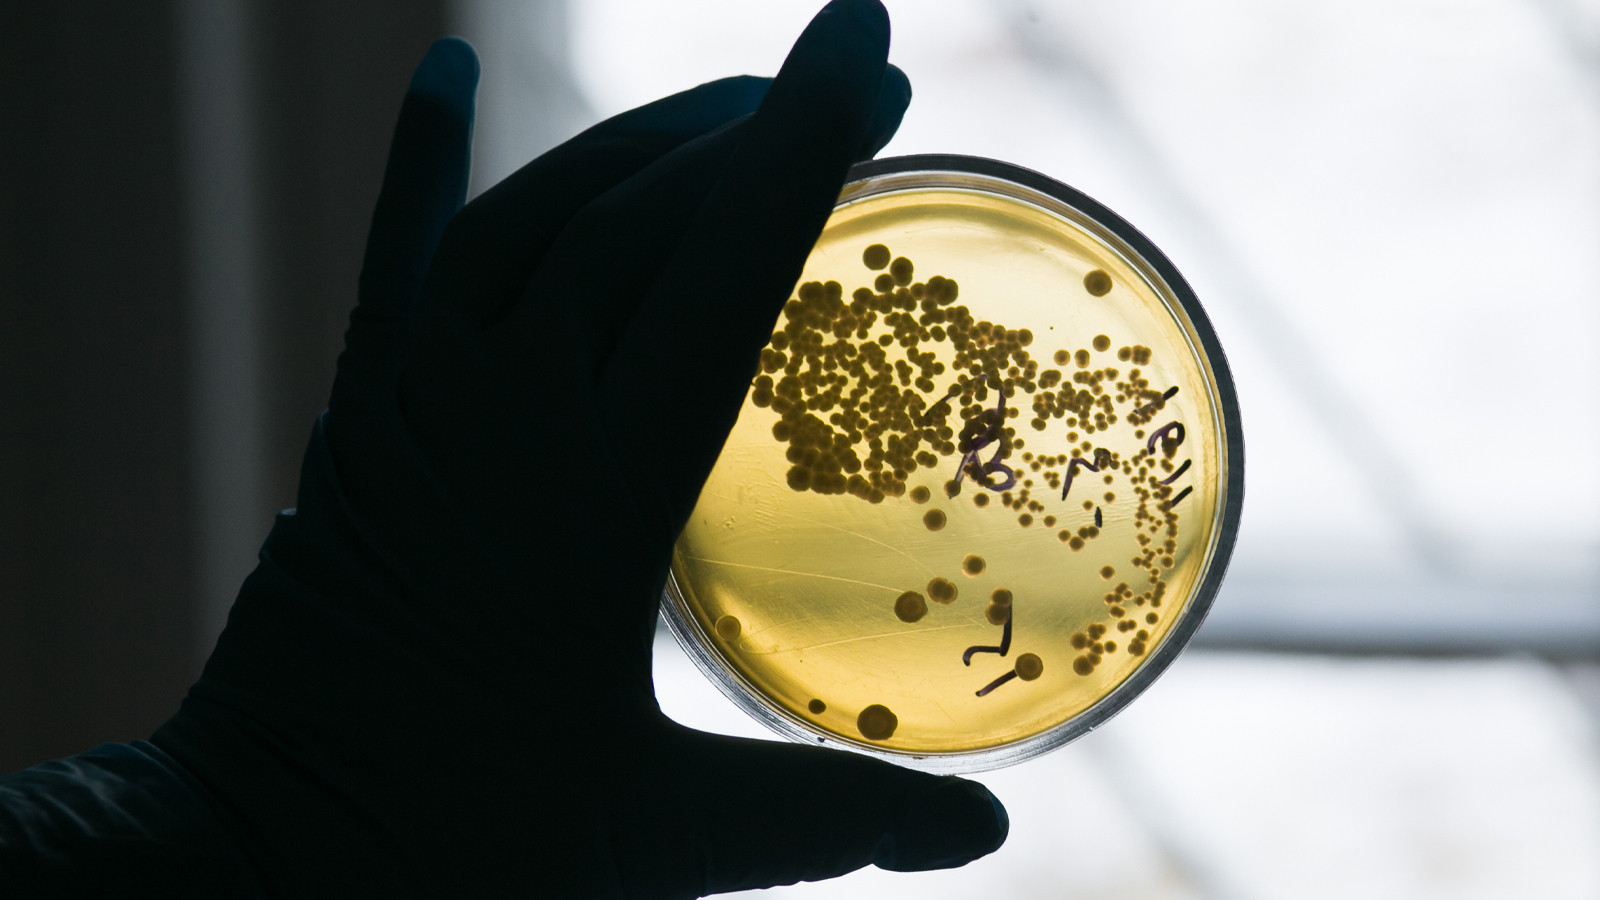

Yeni salgın 2 can aldı: En çok çocukları etkiliyor!
Almanya’da E. Coli (STEC) bakterisi kaynaklı salgında 1’i çocuk 2 kişinin hayatını kaybettiği bildirildi. Teyit edilmeyen 1 ölümün daha bulunduğunu belirten yetkililer, bakterinin özellikle çocukları etkilediğini söyleyerek uyarıda bulundu.